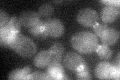
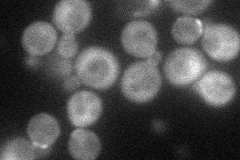
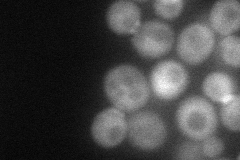
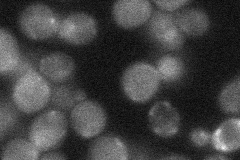
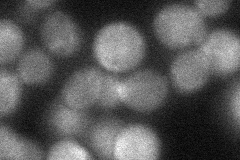
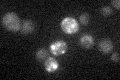

View description
GTPase-activating protein for the polarity-establishment protein Cdc42p; implicated in control of septin organization, pheromone response, and haploid invasive growth
Localization:
Intensity:
Fold change:
Significance:
-
C’ GFP library in SD
bud neckN/A -
N' NOP1pr-GFP in SD
cytosol,bud neck52.3654 -
N' TEF2pr-mCherry in SD
bud neck57.8427 -
N' NATIVEpr-GFP in SD
bud neck25.815 -
N' TEF2pr-VC and Cyto-VN in SD
cytosol40.4023 -
C’ GFP library in SD+DTT

technical problem0N/ANo -
C’ GFP library in SD+H2O2

bud neck23.751.15No -
C’ GFP library in Starvation Media
cytosol16.360.79No -
C’ GFP library on the background of Pup2-DaMP

bud neck -
C’ GFP library on the background of CCT mutant

bud neck22.59831.09739No
